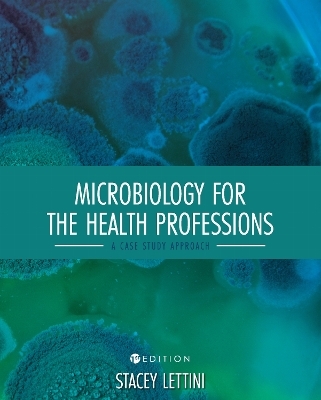
Microbiology for the Health Professions - Stacey Lettini

Microbiology for the Health Professions
A Case Study Approach
Seiten
2021
Cognella, Inc (Verlag)
978-1-7935-1084-6 (ISBN)
Cognella, Inc (Verlag)
978-1-7935-1084-6 (ISBN)
Focuses on the basic microbiology required for students in nursing and allied health professions. The text uses a case study approach to allow students to experience real-life scenarios of infectious disease to discover the epidemiology, pathogenesis, disease manifestation, diagnosis, treatment, and prevention of specific infectious microorganisms.
Microbiology for the Health Professions: A Case Study Approach features a unique focus on the basic microbiology required for students in nursing and allied health professions. The text uses a case study approach to allow students to experience real-life scenarios of infectious disease in order to discover the epidemiology, pathogenesis, disease manifestation, diagnosis, treatment, and prevention of specific infectious microorganisms.
Opening chapters describe the importance of microbiology to the health professions, identify the differences between pathogenic and non-pathogenic microorganisms, and present chemistry basics for microbiology. Students learn about prokaryotic and eukaryotic cell structure, microbial metabolism and growth, the transmission and epidemiology of microorganisms, and mechanisms of infection establishment and pathogenesis. Additional chapters address basic microbial genetics, viruses, parasites, fungal pathogens, nosocomial infections, global microbiology, and more. Each chapter includes an introduction, reflection questions, summaries, key takeaways, case scenarios, and post-reading questions to support the learning experience and increase retention of the material.
Microbiology for the Health Professions is an exemplary and immersive resource for courses and programs in nursing and allied health professions.
Microbiology for the Health Professions: A Case Study Approach features a unique focus on the basic microbiology required for students in nursing and allied health professions. The text uses a case study approach to allow students to experience real-life scenarios of infectious disease in order to discover the epidemiology, pathogenesis, disease manifestation, diagnosis, treatment, and prevention of specific infectious microorganisms.
Opening chapters describe the importance of microbiology to the health professions, identify the differences between pathogenic and non-pathogenic microorganisms, and present chemistry basics for microbiology. Students learn about prokaryotic and eukaryotic cell structure, microbial metabolism and growth, the transmission and epidemiology of microorganisms, and mechanisms of infection establishment and pathogenesis. Additional chapters address basic microbial genetics, viruses, parasites, fungal pathogens, nosocomial infections, global microbiology, and more. Each chapter includes an introduction, reflection questions, summaries, key takeaways, case scenarios, and post-reading questions to support the learning experience and increase retention of the material.
Microbiology for the Health Professions is an exemplary and immersive resource for courses and programs in nursing and allied health professions.
Stacey Lettini is an associate professor of biology at Gwynedd Mercy University, where she teaches courses in ecology, microbiology, and general biology, and supervises student research projects. She holds a Ph.D. in ecology and evolution and B.S. in animal sciences from Rutgers University. Her research interests include the diversity and functional role of bacteria and fungi in soil and freshwater ecosystems.
| Erscheinungsdatum | 21.12.2021 |
|---|---|
| Verlagsort | San Diego |
| Sprache | englisch |
| Maße | 203 x 254 mm |
| Gewicht | 1075 g |
| Themenwelt | Medizin / Pharmazie ► Medizinische Fachgebiete ► Medizinethik |
| Medizin / Pharmazie ► Medizinische Fachgebiete ► Mikrobiologie / Infektologie / Reisemedizin | |
| Naturwissenschaften ► Biologie ► Mikrobiologie / Immunologie | |
| ISBN-10 | 1-7935-1084-9 / 1793510849 |
| ISBN-13 | 978-1-7935-1084-6 / 9781793510846 |
| Zustand | Neuware |
| Informationen gemäß Produktsicherheitsverordnung (GPSR) | |
| Haben Sie eine Frage zum Produkt? |
Mehr entdecken
aus dem Bereich
aus dem Bereich
Biographien von Ärztinnen im 20. und 21. Jahrhundert
Buch | Softcover (2024)
Lehmanns Media (Verlag)
CHF 23,70
Grundlagen, Arzneimittelporträts, Anwendung
Buch | Hardcover (2024)
Urban & Fischer in Elsevier (Verlag)
CHF 95,90


